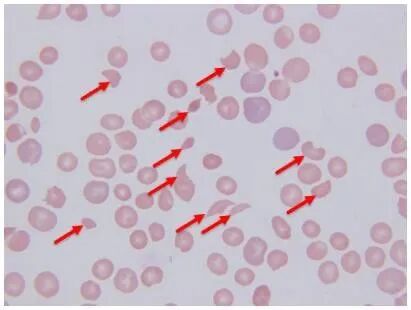

一例血栓性血小板减少性紫癜(TTP)的诊疗历程
在医疗救治的战场上,症状往往是弥漫的硝烟,而检验数据,则是穿透迷雾、指引方向的“火眼金睛”近日,我院成功救治的一例凶险的“血栓性血小板减少性紫癜”患者,正是检验与临床精诚合作的生动写照。
01 一张外周血图片的“无声警报” 9月30日下午,一份普通的血常规标本被送至检验科。血小板6*10^9/L,已触碰复检规则,推片镜检。在显微镜下,我科检验技师以高度的专业敏锐性,捕捉到了一个至关重要的细节——裂片红细胞比例高达2.2%。这个看似微小的数值,却是一个强烈的危险信号。裂片红细胞,是红细胞在流经因微血栓而变得异常狭窄的毛细血管时,被机械性撕裂的产物。它的出现,提示患者体内可能存在广泛的微血管病性溶血。 02 检验沟通为精准医疗划定“生命红线” 检验科没有让这个发现停留在报告单上,立刻拿起电话,与临床医生进行了紧急而深入的沟通:“该患者在外院诊断乏力、血小板低,并输注一个治疗量的血小板,次日出现血尿,病情加重,就诊于我院血液科。此刻患者外周血中发现大量裂片红细胞,乳酸脱氢酶异常升高,胆红素升高,尿素升高,尿蛋白与尿隐血强阳性,并伴有间断发热症状,检验科高度怀疑血栓性血小板减少性紫癜,此类患者输注血小板需极度谨慎,可能加重血栓形成。”这通电话,成为了整个救治流程的第一个关键转折点。TTP是一种罕见的、进展迅猛且致死率高的血液急症,其核心病理是微血管内广泛形成血小板血栓,导致血小板被大量消耗而急剧减少。此时若盲目输注血小板,无异于“为虎作伥”,为血栓形成提供更多“原料”,可能瞬间导致病情恶化,甚至死亡。 正常血液循环图 检验科的预警,为临床医生划下了一条清晰的“生命红线”。临床医生采纳了检验科的建议,在诊断未明、高度怀疑TTP的情况下,顶住了血小板数值极低的压力,果断暂停了常规的血小板输注方案,改为血浆置换。 03 特异性检测锁定“元凶” 随后的检测显示,患者体内的“血管性血友病因子裂解酶”活性重度减低,其抑制物定量呈阳性。这正是导致TTP的根本“元凶”——该酶活性缺失,使得超大分子的血管性血友病因子多聚体无法被正常降解,从而过度激活血小板,在全身微血管内形成弥漫性血栓。 TTP的病例机制 至此,从形态学的初筛(裂片红细胞)到功能学的确诊(ADAMTS13活性检测),检验医学为这例TTP提供了从疑到断的完整证据链,诊断明确无误。 04 检验指标引领治疗航向 诊断明确后,患者立即接受了后续的血浆置换、免疫抑制剂及激素等标准治疗方案。在整个治疗过程中,看着患者的血小板计数从危急值逐步攀升,血红蛋白趋于稳定,临床症状日渐好转,所有参与救治的医护人员都倍感欣慰。 这次与临床的全力配合,深刻地体会到:检验数据的动态变化,客观、精准地描绘了患者从危重到康复的生命曲线。 检验是临床的“侦察兵”,沟通是检验价值的“倍增器”, 精准诊断是有效治疗的“基石”在精准医疗的浪潮中,检验科已不再是传统印象中的“辅助科室”,已经从操作者转变为解读人,从数据输出,走向临床赋能!当检验的“火眼金睛”与临床的“妙手仁心”紧密携手,共同为患者构筑起一道最为坚实的生命防线。

相关新闻
相关新闻